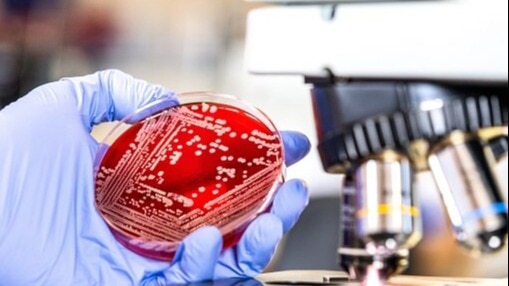
The delay in drug registration and access plans could result in a public health crisis for India, where drug-resistant infections are rapidly escalating. Representational photo The delay in drug registration and access plans could result in a public health crisis for India, where drug-resistant infections are rapidly escalating. Representational photo

India’s battle against antimicrobial resistance hit by delays in drug approvals
A report by Netherlands-based independent non-profit organisation highlights that despite the urgent need for new drugs, only a few firms are in late-stage clinical trials.
- May 24, 2024,
- Updated May 24, 2024 12:12 PM IST
Despite ongoing efforts to tackle rising antimicrobial resistance, India remains at significant risk due to the absence of definitive plans for registering essential new antibiotics.
While a trend seems to be setting in among large research-based pharmaceutical companies scaling down or halting antimicrobial research and development R&D due to commercial non-viability, failure to quicken the pipeline for new antibiotics leaves low- and middle-income countries (LMICs), especially India, at severe risk, industry experts have warned.
Highlighting the problem, a report from the Access to Medicine Foundation, a Netherlands-based independent non-profit organisation, has said that despite the urgent need for new drugs, only a few firms, including GSK, F2G, Innoviva, and Venatorx, are in late-stage clinical trials.
While organisations like the Global Antibiotic Research & Development Partnership (GARDP) have made progress, many crucial medical breakthroughs may not reach India promptly along with other LMICs. The report identified five LMICs, including China, India, Mexico, South Africa, and Thailand, where concrete registration commitments continue to exist. However, the fate of life-saving antibiotics is uncertain for 108 out of the 113 LMICs assessed.
“If all five late-stage projects successfully make it to the market, 160,000 lives could be saved globally each year. To achieve this, pharmaceutical companies and their partners must come together to ensure that these medicines are accessible, affordable, and available to people who need them the most,” said Marijn Verhoef, Director of Operations and Research, Access to Medicine Foundation.
The India Impact
India, bearing one of the highest burdens of carbapenem-resistant E. coli — a primary pathogen for uncomplicated urinary tract infections (uUTIs) — is particularly vulnerable. GSK, for example, conducted its Phase III clinical trials for uUTIs in India, highlighting the critical need. Despite developing both adult and paediatric formulations of the antibiotic gepotidacin, GSK lacks structured plans to make these treatments widely accessible and affordable in India, as per the report. This absence of clarity raises concerns about whether these vital drugs will reach those who need them most, the report indicated.
Adding to the challenge, Venatorx’s plans to introduce cefepime-taniborbactam, a promising new antibiotic for multi-drug-resistant infections, through its partnership with GARDP, come with significant caveats. While there are intentions to make this drug available in 64 LMICs, including India, through export waivers and an international procurement agency, concrete steps remain elusive.
Why should India worry?
The World Health Organization (WHO) found only 12 new antibiotics gained market approval between 2017 and 2021, with just two representing new chemical classes, the report noted. The delay in drug registration and access plans could result in a public health crisis for India, where drug-resistant infections are rapidly escalating.
“Drug-resistant infections are on the rise in India, and the development of new drugs is urgently required. However, launching new drugs depends on investment, political and legal frameworks, a conducive environment, and technology for clinical trials and delivery systems. India should lead the world due to its huge market potential but has failed to take the lead because of a lack of infrastructure, trained human resources, and a supportive environment,” said Dr Jugal Kishore, Director Professor, community medicine at Vardhman Mahavir Medical College and Safdarjung Hospital.
“Compliance with standards and the quality of procedures are poor. There is no institutional support or incentive to carry out research. Instead, it is quite humiliating, laborious, and poorly paid. Everyone looks at researchers with suspicion of personal benefit and corruption. We are critically facing drug resistance in TB, leprosy, malaria, fungal infections, pneumonia, UTIs, and many other infections. The government should urgently ease all bottlenecks before it is too late,” he said.
The development holds importance for India as the country launched the National Action Plan on Antimicrobial Resistance in 2017.
Furthermore, the central government has been promoting rational use of antibiotics.
“Government’s efforts to promote the rational use of antibiotics and strengthen surveillance systems have yielded positive results, instilling hope in our fight against this critical issue. However, the critical issue of drug approval delays, which impede our battle against antibiotic resistance. The situation's urgency is apparent: we must expedite the registration and distribution of new antibiotics to combat drug-resistant infections effectively,” said Dr K Madan Gopal, Advisor, Public Health Administration, National Health Systems Resource Centre (NHSRC), government’s policy think tank.
“Given these findings, it is of utmost importance for pharmaceutical companies, policymakers, and international health organisations to come together. We must expedite the approval process and ensure the accessibility and affordability of these life-saving medications,” he said.
Despite ongoing efforts to tackle rising antimicrobial resistance, India remains at significant risk due to the absence of definitive plans for registering essential new antibiotics.
While a trend seems to be setting in among large research-based pharmaceutical companies scaling down or halting antimicrobial research and development R&D due to commercial non-viability, failure to quicken the pipeline for new antibiotics leaves low- and middle-income countries (LMICs), especially India, at severe risk, industry experts have warned.
Highlighting the problem, a report from the Access to Medicine Foundation, a Netherlands-based independent non-profit organisation, has said that despite the urgent need for new drugs, only a few firms, including GSK, F2G, Innoviva, and Venatorx, are in late-stage clinical trials.
While organisations like the Global Antibiotic Research & Development Partnership (GARDP) have made progress, many crucial medical breakthroughs may not reach India promptly along with other LMICs. The report identified five LMICs, including China, India, Mexico, South Africa, and Thailand, where concrete registration commitments continue to exist. However, the fate of life-saving antibiotics is uncertain for 108 out of the 113 LMICs assessed.
“If all five late-stage projects successfully make it to the market, 160,000 lives could be saved globally each year. To achieve this, pharmaceutical companies and their partners must come together to ensure that these medicines are accessible, affordable, and available to people who need them the most,” said Marijn Verhoef, Director of Operations and Research, Access to Medicine Foundation.
The India Impact
India, bearing one of the highest burdens of carbapenem-resistant E. coli — a primary pathogen for uncomplicated urinary tract infections (uUTIs) — is particularly vulnerable. GSK, for example, conducted its Phase III clinical trials for uUTIs in India, highlighting the critical need. Despite developing both adult and paediatric formulations of the antibiotic gepotidacin, GSK lacks structured plans to make these treatments widely accessible and affordable in India, as per the report. This absence of clarity raises concerns about whether these vital drugs will reach those who need them most, the report indicated.
Adding to the challenge, Venatorx’s plans to introduce cefepime-taniborbactam, a promising new antibiotic for multi-drug-resistant infections, through its partnership with GARDP, come with significant caveats. While there are intentions to make this drug available in 64 LMICs, including India, through export waivers and an international procurement agency, concrete steps remain elusive.
Why should India worry?
The World Health Organization (WHO) found only 12 new antibiotics gained market approval between 2017 and 2021, with just two representing new chemical classes, the report noted. The delay in drug registration and access plans could result in a public health crisis for India, where drug-resistant infections are rapidly escalating.
“Drug-resistant infections are on the rise in India, and the development of new drugs is urgently required. However, launching new drugs depends on investment, political and legal frameworks, a conducive environment, and technology for clinical trials and delivery systems. India should lead the world due to its huge market potential but has failed to take the lead because of a lack of infrastructure, trained human resources, and a supportive environment,” said Dr Jugal Kishore, Director Professor, community medicine at Vardhman Mahavir Medical College and Safdarjung Hospital.
“Compliance with standards and the quality of procedures are poor. There is no institutional support or incentive to carry out research. Instead, it is quite humiliating, laborious, and poorly paid. Everyone looks at researchers with suspicion of personal benefit and corruption. We are critically facing drug resistance in TB, leprosy, malaria, fungal infections, pneumonia, UTIs, and many other infections. The government should urgently ease all bottlenecks before it is too late,” he said.
The development holds importance for India as the country launched the National Action Plan on Antimicrobial Resistance in 2017.
Furthermore, the central government has been promoting rational use of antibiotics.
“Government’s efforts to promote the rational use of antibiotics and strengthen surveillance systems have yielded positive results, instilling hope in our fight against this critical issue. However, the critical issue of drug approval delays, which impede our battle against antibiotic resistance. The situation's urgency is apparent: we must expedite the registration and distribution of new antibiotics to combat drug-resistant infections effectively,” said Dr K Madan Gopal, Advisor, Public Health Administration, National Health Systems Resource Centre (NHSRC), government’s policy think tank.
“Given these findings, it is of utmost importance for pharmaceutical companies, policymakers, and international health organisations to come together. We must expedite the approval process and ensure the accessibility and affordability of these life-saving medications,” he said.
